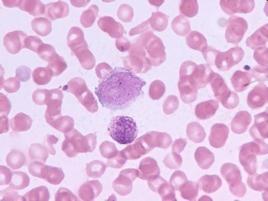
慢性嗜酸性粒細胞肺炎 慢性嗜酸性粒細胞肺炎

病因
慢性嗜酸性粒細胞肺炎 CEP的病因可能與單純型嗜酸粒細胞增多症相似,亦可能是自身免疫性疾病。由Ⅲ、Ⅳ型變態反應的協同作用所引起,也可由Ⅱ型變態反應所致。儘管確切的免疫發病機制還不清楚,但許多證據表明,嗜酸粒細胞在對肺組織損傷中發揮著初始的重要的作用。
在臨床症狀發作前,周圍血中及骨髓中嗜酸粒細胞數目已增多,BALF中,也是以嗜酸粒細胞為主,在肺實質和微血管上可見嗜酸粒細胞衍化顆粒蛋白(EDGP),與對照組相比,CEP病人的BALF中的EDGP也是增加的、包括Ⅱ型組織相溶性抗原在內的BALF衍化的嗜酸粒細胞表達激活標記物也增高,雖然這些在CEP中調節嗜酸粒細胞激活和脫顆粒的過程中並不清楚,但表明這些嗜酸粒細胞是活化的。
從Ⅱ型組織相溶性抗原和其他激活標記物是在BALF中而非血液中的衍生嗜酸粒細胞表達增加說明免疫炎症反應是局限在肺中。在體外,免疫球蛋白能放大嗜酸粒細胞趨化和脫顆粒。免疫循環複合物和IgE滴度的升高與疾病的臨床突發有關。到目前為止,嗜酸粒細胞活化和免疫球蛋白之間的關係還不清楚。
體徵
慢性嗜酸性粒細胞肺炎 患者呈急性熱病容,面頰緋紅,鼻翼扇動,皮膚灼熱、乾燥,口角及鼻修軸單純皰疹;病變廣泛時可出現發紺;有敗血症者,可出現皮膚、黏膜出血點、鞏膜黃染;累及腦膜時,可有頸抵抗及出現病理性反射。心率增快,有時心律不齊。早期肺部體徵無明顯異常,僅有胸廓呼吸運動幅度減小,輕度叩濁,呼吸音減低及胸膜摩擦音。肺實變時有叩診呈濁音、觸覺語顫增強及支氣管呼吸音等典型體徵。消散期可聞及濕羅音,重症患者有腸充氣,上腹部牙痛多與炎症累及膈胸膜有關。感染嚴重時可伴發休克、急性呼吸窘迫綜合徵及神經症狀,表現為神志模糊、煩燥、呼吸困難、嗜睡、譫妄、昏迷等。
生理
慢性嗜酸性粒細胞肺炎 肺損害表現為肺泡和間質以嗜酸粒細胞為主的浸潤,並見有相關的巨噬細胞和少到中等的淋巴細胞和偶爾的漿細胞。肺泡壁結構破壞,毛細血管內皮局限性水腫,灶性Ⅱ型上皮細胞增生,肺泡蛋白滲出和多核組織細胞浸潤,有1/3病例有增生的阻塞性的細支氣管炎的表現,也可以看到輕度非壞死的微血管炎,主要影響小靜脈,少數病例(不到20%)可見明顯的壞死、嗜酸粒細胞微膿腫、或非乾酪樣肉芽腫,縱隔內的淋巴活檢標本見淋巴增生和嗜酸粒細胞浸潤。
診斷
慢性嗜酸性粒細胞肺炎 根據病史、病程、兩肺存在哮喘音、周圍血嗜酸粒細胞增高及胸部X線陰影可作出臨床診斷。不典型者,可經肺活檢進行病理檢查,以明確診斷。必要時可用潑尼松試驗性治療以幫助診斷。
實驗室檢查:白細胞增多>10×109/L。60%~90%的病人周圍血嗜酸粒細胞增多(>6%),但周圍血嗜酸粒細胞缺乏也不能排除該病。痰中可找到較多的嗜酸粒細胞。血沉增快(>20mm/h)。1/3的病例血IgE升高。
其他輔助檢查:肺功能的異常和嚴重程度與疾病的階段有關,典型者為中、重度的限制性通氣功能障礙、DLCO的下降。肺泡-動脈氧的梯度的升高,如果伴有哮喘則有阻塞性的改變。X線表現與胸膜相對的周圍漸進的密度增強的浸潤影,邊緣不清,呈非節段性、亞段和葉的分布,多位於肺外周2/3,而肺門處較透明,故稱為“肺水腫反轉形狀”,陰影易在原處復發。潑尼松治療後陰影很快吸收。與Loffler’綜合徵相反,CEP的肺浸潤為非遷移性,很少有胸腔積液。不典型的X線表現包括結節狀浸潤、瀰漫性毛玻璃樣的肺泡填充征。胸部CT檢查對於臨床懷疑而X線表現不典型的病例可作CT檢查,CT的表現,在症狀發作的前幾周,大部分表現為典型的密度區、周圍局部的肺泡實變,當症狀持續2個月以上,可見有條索帶狀不透光區,並見縱隔淋巴結腫大。
鑑別
慢性嗜酸性粒細胞肺炎 許多嚴重的下呼吸道疾病如肺結核、肺膿腫、支原體肺炎、肺癌和多種急性感染性疾病如麻疹、百日咳、急性扁桃體炎等在發病時常伴有急性氣管支氣管炎的症狀,均可引起咳嗽。注意仔細詢問病史,如是否暴露於毒性物質,有否吸菸史,是否有其他系統症狀,疫苗接種史等,結合流行病學資料,根據每種疾病的特點詳加檢查,以資鑑別。流行性感冒的症狀與急性支氣管炎頗為相似,但前者常呈規模不一的流行性暴發,起病急驟,全身症狀明顯,有高熱、頭痛和全身肌肉酸痛,依據病毒的分離和補體結合試驗可確診應,注意排除囊性肺纖維化及低丙種球蛋白血症。
治療
慢性嗜酸性粒細胞肺炎 CEP的鑑別診斷包括感染,特別是結核和真菌尤其是隱球菌的感染、結節病、Loeffler`s綜合徵等。潑尼松是CEP最主要的治療藥物,大多數病例用潑尼松(40mg/d,為最初劑量)治療後,6h內退熱,24~48h呼吸困難、咳嗽和嗜酸粒細胞浸潤減輕,低氧血症在2~3天得到緩解,1~2周X線改善,快者2~4天。症狀完全緩解在2~3周,X線在2個月內恢復正常。待症狀好轉和肺部症狀吸收後逐漸減量(約10~14天),療程4~6個月,可並發嚴重的呼吸衰竭或ARDS。
預防
慢性嗜酸性粒細胞肺炎 預後:CEP預後一般良好,但偶可致死。未經治療的病人很少能緩解,經糖皮質激素治療的病人病死率明顯下降。但是如果潑尼松過快減量或間斷時,58%~80%的病人復發,復發常出現在原來的解剖部位上,則需1~2年的治療,25%的病人需長期維持劑量(2.5~10mg/d)直到疾病癒合。儘管沒有指標表明病人會復發或需要長期維持治療,但短程(1~3個月)治療常致復發,且可多次復發,但再次服用潑尼松仍然有效。1.根治原發病。2.增強體質,預防感冒。
CEP又稱遷延型嗜酸粒細胞增多症、慢性粒細胞性肺炎。該病任何年齡均可發病,但高峰年齡是30~40歲,婦女幾乎是男性的2倍。大部分病例為高加索人,約1/3到1/2的患者有過敏性鼻炎或鼻息肉等病史,另外有2/3的病人有成人發作性哮喘或有其他呼吸道症狀。